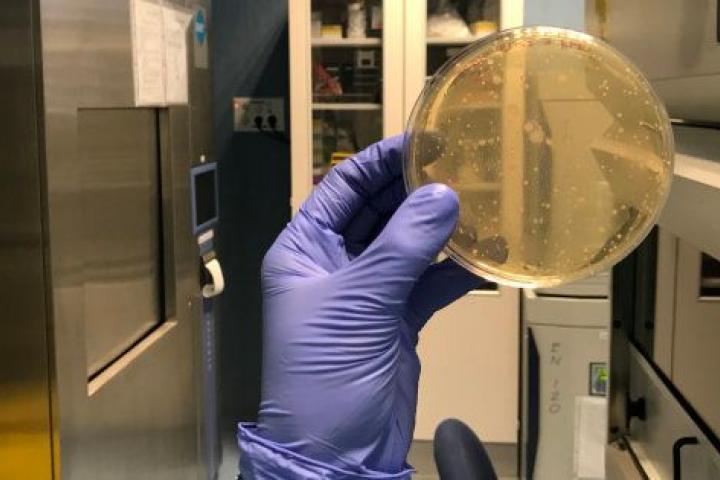

Del agar al hangar: cinco visitas que han enriquecido mi 2018
Como dije hace unos días, al recoger el premio que me ha concedido la Fundación Grünenthal por el reportaje Crecer con dolor, el periodismo es magia, sobre todo para quienes nos dedicamos a ello. Explicar historias es muy gratificante porque nos permite conocer a gente interesante y compartir momentos y encuentros enriquecedores.
A lo largo del 2018, he visitado muchas instalaciones y equipamientos, relacionados con la ciencia y la cultura, en donde he disfrutado como un niño en un parque de atracciones. A continuación, reseño las cinco visitas principales que me han ayudado a crecer y aprende:
Instituto de Investigación en Ciencias de la Alimentación (CIAL) (Madrid)
El 9 de febrero tuve el honor de recibir una visita guiada personalizada a una instalación poco conocida, pero muy importante en cuanto a innovación y transferencia del conocimiento que alberga.
El CIAL es un centro del Consejo Superior de Investigaciones Científicas (CSIC) y de la Universidad Autónoma de Madrid (UAM) que cuenta con una tecnología puntera y sofisticada que les permite investigar con el fin de avanzar en el conocimiento de los productos alimentarios y en el funcionamiento del cuerpo humano, especialmente, frente a determinados alimentos. Son quienes relacionan la ciencia y la gastronomía o la seguridad alimentaria y la calidad sensorial del vino.

Hacen ciencia básica y ciencia aplicada. Allí estudian, por ejemplo, la actividad biológica de proteínas, la interacción de ingredientes bioactivos con la microbiota humana o las propiedades beneficiosas en la salud de las bacterias probióticas. Y también mejoran productos y desarrollan alimentos enriquecidos o revalorizan los subproductos de la industria alimentaria para obtener nuevos alimentos y bebidas saludables.
Las salas que más me fascinaron fueron la Plataforma de Metabolómica, donde experimentan con aparatos de altísima precisión, únicos en un centro público en España; y el Simulador Gastrointestinal Dinámico (simgi®). En éste último fue donde más disfruté. Vestido con atuendo llamativo para protegerme y proteger los experimentos, pude ver, además de decenas de placas de Petri con colonias de bacterias de yogur viviendo en el agar, unos aparatos y tubos que simulaban un aparato digestivo: estómago, intestino delgado, intestino grueso... Allí estudian cómo trabaja cada fase de la digestión por separado. Por cierto, si alguien quiere donar sus heces, allí necesitan de su microbiota...
Sincrotrón ALBA (Cerdanyola del Vallès)
El 5 de mayo se celebró el ALBA Open Day, la Jornada de Puertas Abiertas del Sincrotrón ALBA. Según la organización, esta séptima edición fue la más exitosa, ya que asistieron 2.321 personas.
Lo cierto es que el evento estaba muy bien organizado. Había decenas de puntos de divulgación a lo largo del recorrido, ya fuesen paneles con pósteres o infografías o trabajadores del sincrotrón ofreciendo su conocimiento in situ. Nadie se quedaba fuera: adultos y niños tenían algo con lo que entretenerse (y aprender).
Fue una buena oportunidad para comprobar que la ciencia interesa. Al menos, eso demostró la gran afluencia de público. Y también fue una buena ocasión para disfrutar de esa espectacular instalación que tenemos en Cerdanyola del Vallès.

También fue muy interesante escuchar a los físicos e ingenieros explicándonos su trabajo diario y aceptando preguntas con nuestras dudas. Ese día, excepcionalmente, hacen un gran esfuerzo por divulgar su conocimiento en un lenguaje sencillo. Y eso, hay que reconocérselo.
¿Sabías que los electrones deben ser impulsados para correr con fuerza (aunque no todos con la misma intensidad)? ¿Sabías que hay potentes imanes que los guían para que sigan la trayectoria que interesa a los científicos? Gracias a ellos descubrí qué hace un sincrotrón, cuestiones básicas de física y de la luz y que, lamentablemente, el Sincrotrón Alba solo tiene en macha ocho proyectos de los 30 que podría contener.
Biblioteca-Museo Víctor Balaguer (Vilanova i la Geltrú)
El 26 de abril estuve de visita entre los bastidores de la Biblioteca-Museo Víctor Balaguer, guiado -de forma personalizada- por su directora, Mireia Rosich. La idea era descubrir, para darlo a conocer yo después en este blog, aquello que no puede ver cualquier visitante. Y es que el almacén de la Biblioteca-Museo Víctor Balaguer esconde alrededor del 80% del total de su fondo.
Cuando entré en los almacenes, me encantó ver ese largo pasillo con armarios compactos que conservan piezas patrimoniales de cerámica o del mundo egipcio, frente a plataformas correderas de las que cuelgan cientos de cuadros y obras de artistas importantes en la historia del arte. Cada paso que daba suponía descubrir algo nuevo. También había un gran espacio donde, cubiertas con plásticos, se guardaban más de una decena de grandes esculturas.

Fue interesante descubrir cómo se las tienen que arreglar para dar visibilidad al fondo que no está expuesto (con exposiciones temporales o abriendo puntualmente los almacenes) y cómo les preocupa la posible llegada de nuevas piezas que no podrían conservar en condiciones adecuadas debido a la saturación de los almacenes actuales.
También me resultó muy enriquecedora la conversación con Almudena Domínguez, catedrática de Arqueología y directora del Máster en Museos: Educación y Comunicación de la Universidad de Zaragoza. Ella me explicó perfectamente cuál es la situación actual de los museos del mundo en cuanto a la ocupación y gestión de sus centros de conservación de colecciones.
American Museum of Natural History (Nueva York)
No me voy a extender demasiado hablando de este museo científico archiconocido que visité durante mis vacaciones de agosto a Estado Unidos. En primer lugar, porque todos lo hemos visto alguna vez en el cine o la televisión y, en segundo lugar, porque mi visita fue más rápida que lo que se tarda en leer este post. No fue una visita fugaz porque no me gustase lo que vi, sino porque no lo tomé como una prioridad en mi circuito por Manhattan y el tiempo se nos echó encima.

Si vas a Nueva York con niños, ¡no te lo puedes perder! Es realmente entretenido y divulgativo ver con calma esas recreaciones de ecosistemas, paisajes y escenas de naturaleza para adentrarse en cómo vive cualquier animal del mundo en su hábitat natural. Y también se puede disfrutar de meteoritos y un sinfín de explicaciones para entender el sistema solar y el espacio.
Solo por lo famoso que es este museo, ya vale la pena visitarlo. Es como estar dentro de una película. Pero, además, es necesario dejarse obnubilar por las grandes piezas como la ballena azul, la gran canoa o la titanosauria. Quizá le falta actualizarse y pasar de ser una exposición pasiva, a integrar algunos elementos que permitan la interacción con las escenas. Así llamaría más la atención de los visitantes.
Centro de Estudios Superiores de la Aviación (CESDA) (Reus)
El 3 de mayo estuve en la escuela de pilotos de aviación comercial CESDA. Se trata de un centro de estudios vinculado a la Universitat Rovira i Virgili (URV). Allí, pude conversar con cinco futuros pilotos. Fue más que interesante conocer qué estudian, qué les parecen sus estudios y cómo ven el futuro de la profesión.
En Jóvenes que quieren llegar muy arriba retraté estas impresiones que me explicaron y pude descubrir que un alumno o alumna de segundo curso, con solo 20 años, ya vuela en solitario (sin instructor) durante horas.

Marina me enseñó el hangar donde guardaban la avioneta que esa misma mañana la había llevado a Pamplona, desde Reus, y me explicó, con la ilusión propia de un niño pequeño que te enseña su juguete, qué pasos, botones y comprobaciones tiene que hacer antes de un vuelo.
Esta visita fue muy gratificante y me ayudó a comprender mejor la profesión de piloto y a conocer las razones que les mueve.
No quisiera acabar este resumen de las principales visitas de mi 2018 sin dar las gracias a todas las personas que me han abierto sus puertas y que me han atendido y acompañado en cada visita.
